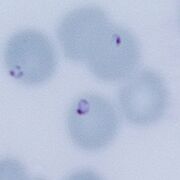
Single fine early rings similar to malaria
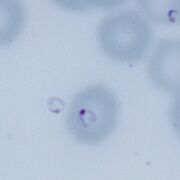
Free parasite lying outside of erythrocyte
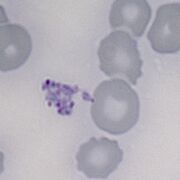
A group of parasites appearing as a mass outside of erythrocytes

BABESIA Gallery
From MalariaETC
Click on any image for single screen display
Simple ring forms
Note the close resemblance to P.falciparum early trophoziites
-
Single fine early rings similar to malaria
-
Many parisite containing red cells, note the marked variability of form
-
Double dot forms may be seen
-
Multiply parasitised erythrocytes
Free parasites
A useful diagnostic feature that is exceptionally rare in malaria
-
Free parasite lying outside of erythrocyte
-
A group of parasites appearing as a mass outside of erythrocytes
Complex forms
-
Elongated gametocyte curved form
-
Elongated gametocyte longer form
"Maltese cross" forms
The difficult to find (and often quite disappointing "diagnostic form"
-
Two slightly untidy Maltese Cross forms form
-
Mature Maltese Cross
-
Another nice maltese cross